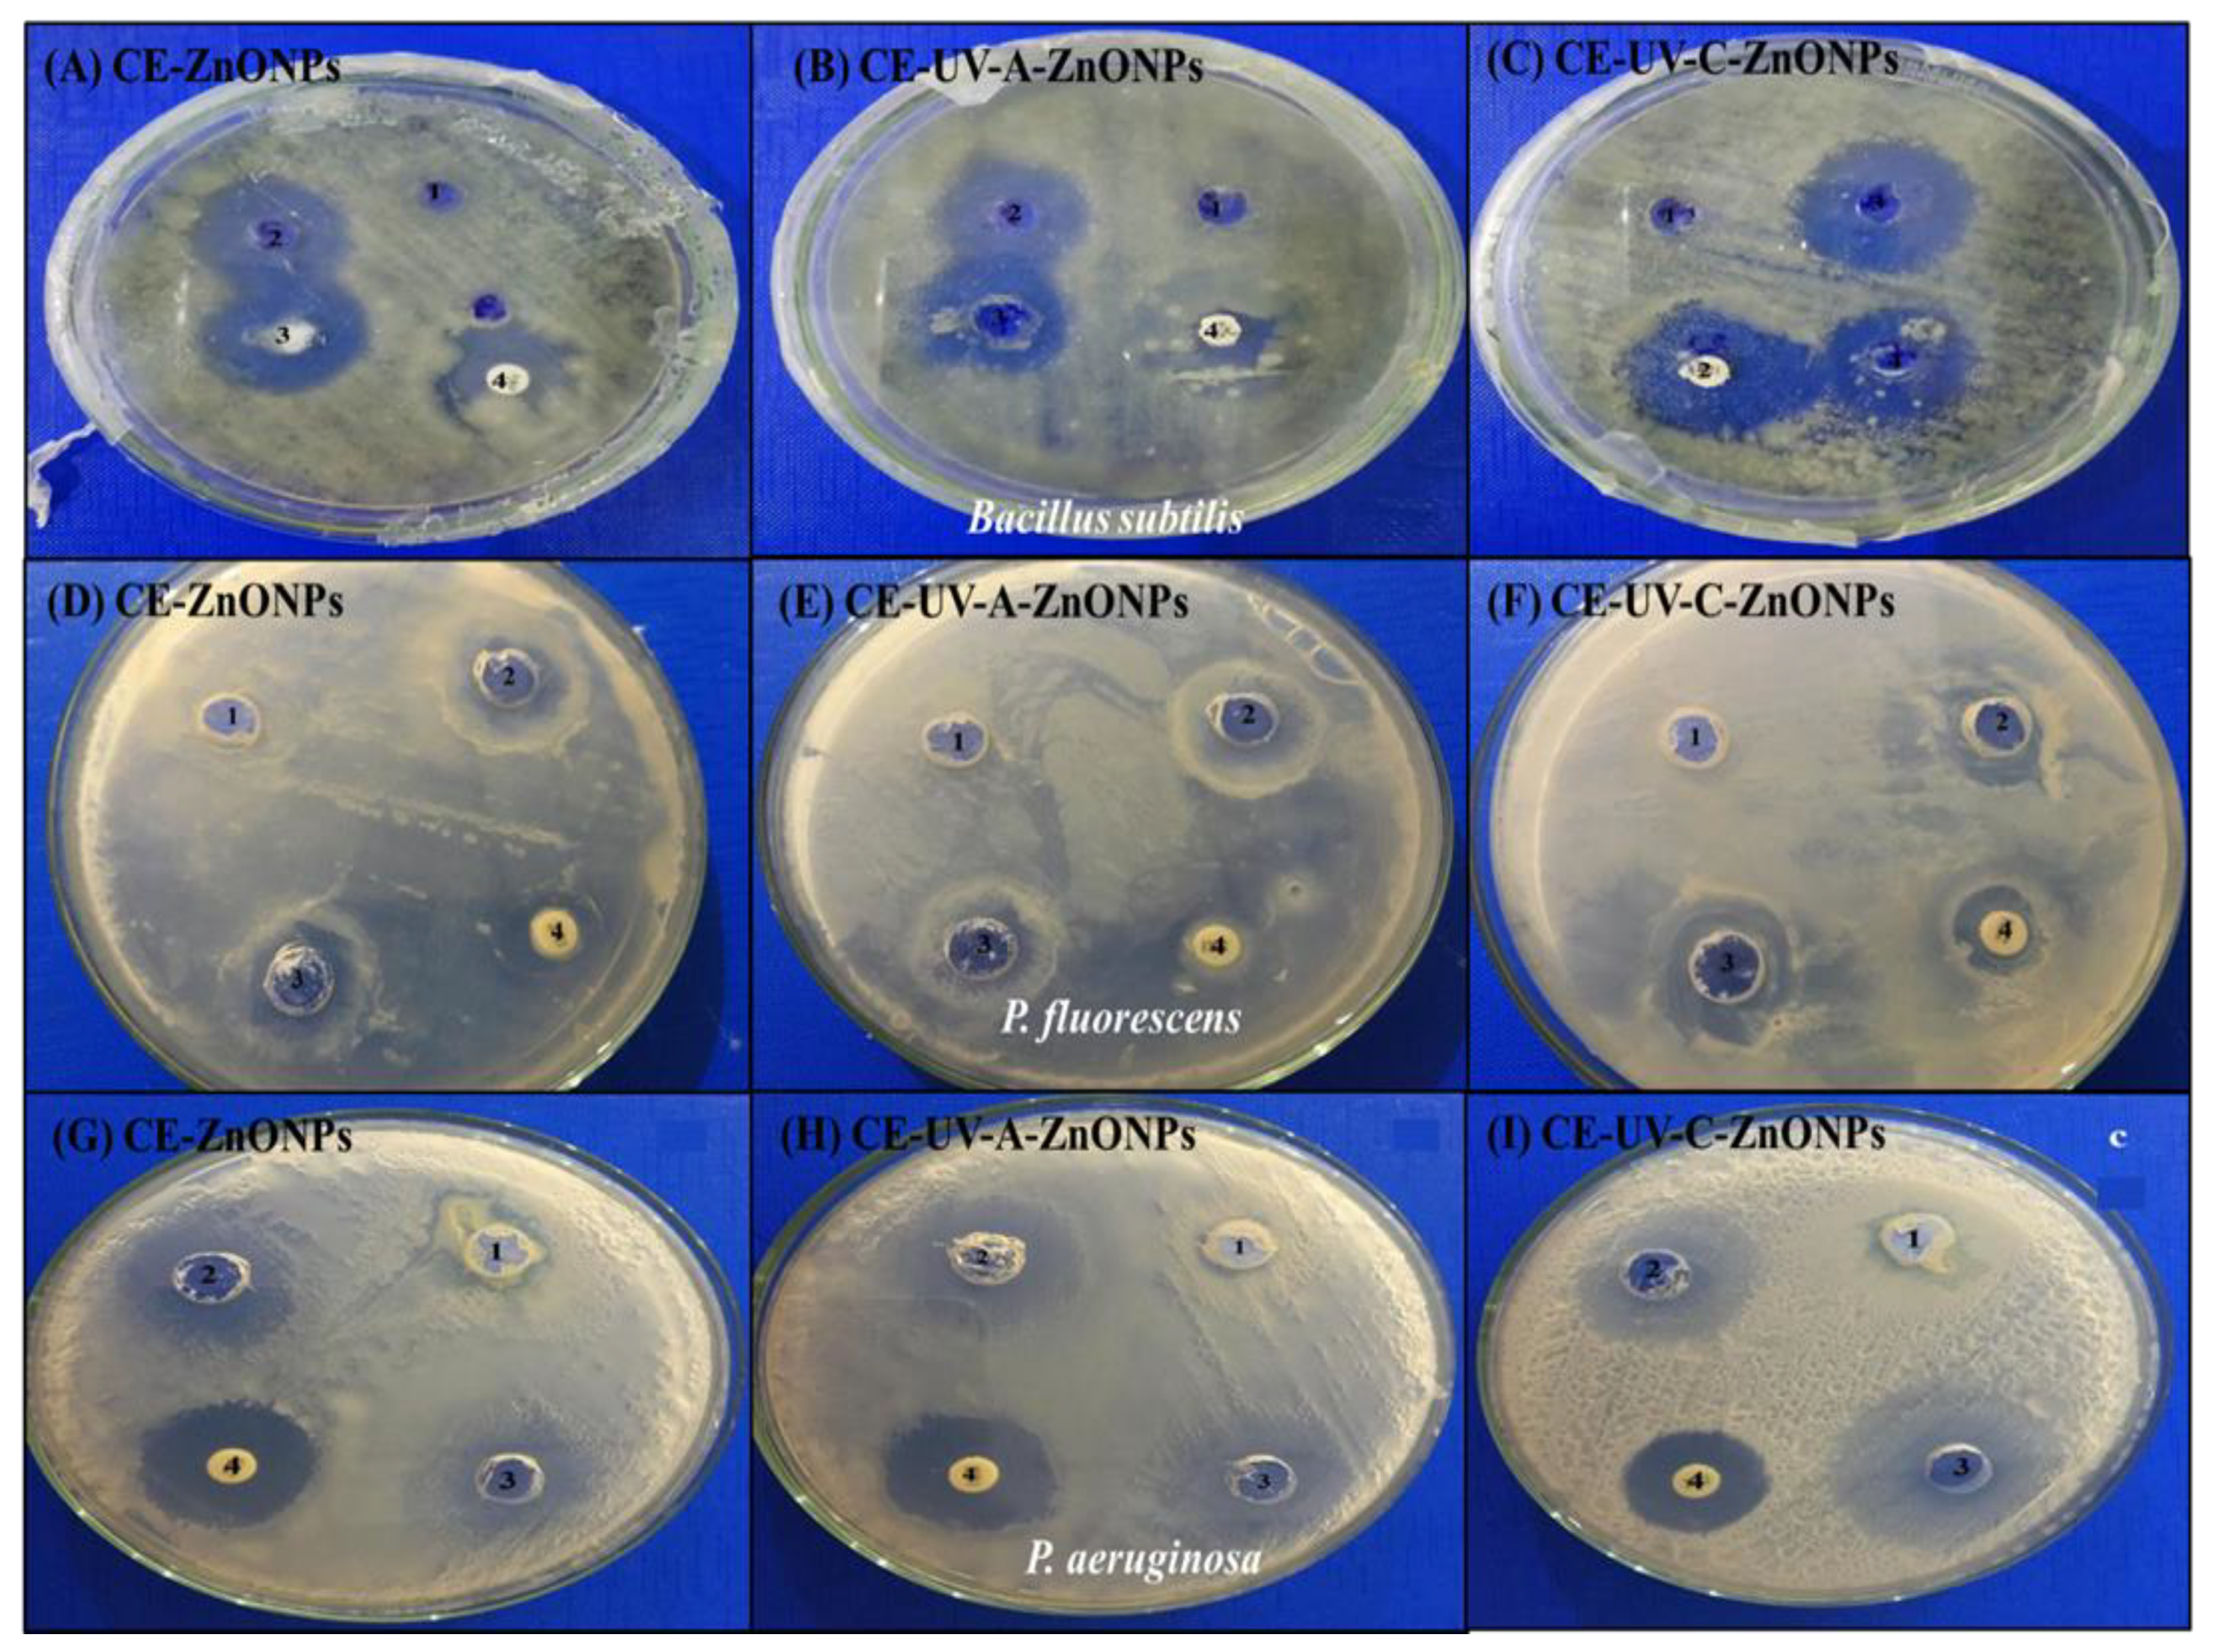

Effect of UV Irradiation (A and C) on Casuarina equisetifolia-Mediated Biosynthesis and Characterization of Antimicrobial and Anticancer Activity of Biocompatible Zinc Oxide Nanoparticles
Abstract
:1. Introduction
2. Materials and Methods
2.1. Preparation of Casuarina equisetifolia Leaf Extract
2.2. Phytochemical Analysis of Casuarina equisetifolia
2.2.1. Total Phenolic Contents
2.2.2. Total Flavonoid Contents
2.2.3. Free Radical Scavenging Activity (FRSA)
2.3. UV-Mediated Green Synthesis of ZnONPs
2.4. Characterization of UV-Mediated ZnONPs
2.4.1. UV-Visible Spectroscopy
2.4.2. Attenuated Total Reflection-Fourier Transform Infrared Spectroscopy (ATR-FTIR)
2.4.3. Scanning Electron Microscopy (SEM) and Energy-Dispersive X-Ray (EDX) Analyses
2.4.4. X-Ray Diffraction Analysis
2.5. Antibacterial Activity of Green-Synthesized ZnONPs
2.6. Anti-Cancerous Activity of Green-Synthesized ZnONPs
2.6.1. Cell Viability Assay by MTT
2.6.2. Measurement of Intracellular Reactive Oxygen and Nitrogen Species (ROS/RNS)
2.6.3. Measurement of Mitochondrial Membrane Potential (MMP)
2.6.4. Caspase-3 Gene Expression and Caspase-3/7 Activity
2.7. Biocompatibility Studies
2.7.1. Brine Shrimp Lethality Assay
2.7.2. Biocompatibility with Human Red Blood Cells (hRBCs)
2.8. Statistical Data Analysis
3. Results
3.1. Phytochemical Analysis of Casuarina equisetifolia
3.1.1. Total Phenolic Contents (TPC) of C. equisetifolia
3.1.2. Total Flavonoid Contents (TFC) of C. equisetifolia
3.2. Free Radical Scavenging Activity (FRSA)
3.3. Characterization of ZnONPs
3.3.1. UV-Visible Spectroscopy
3.3.2. Attenuated Total Reflection-Fourier Transform Infrared Spectroscopy (ATR-FTIR)
3.3.3. Scanning Electron Microscopy (SEM) Analysis
3.3.4. Energy-Dispersive X-Ray (EDX) Analysis
3.3.5. X-Ray Diffraction Analysis
3.4. Antibacterial Activity of Green-Synthesized ZnONPs
3.5. Anti-Cancerous Activities of Green-Synthesized ZnONPs
3.5.1. Cell Viability Assay by MTT
3.5.2. Measurement of Intracellular ROS/RNS
3.5.3. Measurement of Mitochondrial Membrane Potential (MMP)
3.5.4. Caspase-3 Gene Expression and Caspase-3/7 Activity
3.6. Biocompatibility Studies of Green-Synthesized ZnONPs
3.6.1. Brine Shrimp Lethality Assay
3.6.2. Biocompatibility with Human Red Blood Cells (hRBCs)
4. Conclusions
Author Contributions
Funding
Institutional Review Board Statement
Informed Consent Statement
Data Availability Statement
Acknowledgments
Conflicts of Interest
References
- Parveen, K.; Banse, V.; Ledwani, L. Green synthesis of nanoparticles: Their advantages and disadvantages. In AIP Conference Proceedings; AIP Publishing LLC: Melville, NY, USA, 2016. [Google Scholar]
- Abdelghany, T.; Al-Rajhi, A.M.; Al Abboud, M.A.; Alawlaqi, M.; Magdah, A.G.; Helmy, E.A.; Mabrouk, A.S. Recent advances in green synthesis of silver nanoparticles and their applications: About future directions. A review. BioNanoScience 2018, 8, 5–16. [Google Scholar] [CrossRef]
- Jha, A.K.; Prasad, K.; Kumar, V.; Prasad, K. Biosynthesis of silver nanoparticles using Eclipta leaf. Biotechnol. Prog. 2009, 25, 1476–1479. [Google Scholar] [CrossRef] [PubMed]
- Osman, D.A.M.; Mustafa, M.A. Synthesis and characterization of zinc oxide nanoparticles using zinc acetate dihydrate and sodium hydroxide. J. Nanosci. Nanoeng. 2015, 1, 248–251. [Google Scholar]
- Singh, J.; Dutta, T.; Kim, K.-H.; Rawat, M.; Samddar, P.; Kumar, P. ‘Green’synthesis of metals and their oxide nanoparticles: Applications for environmental remediation. J. Nanobiotechnol. 2018, 16, 1–24. [Google Scholar] [CrossRef] [PubMed]
- Zhang, D.; Ma, X.-l.; Gu, Y.; Huang, H.; Zhang, G.-W. Green synthesis of metallic nanoparticles and their potential applications to treat cancer. Front. Chem. 2020, 8, 799. [Google Scholar] [CrossRef]
- Ogunyemi, S.O.; Abdallah, Y.; Zhang, M.; Fouad, H.; Hong, X.; Ibrahim, E.; Masum, M.M.I.; Hossain, A.; Mo, J.; Li, B. Green synthesis of zinc oxide nanoparticles using different plant extracts and their antibacterial activity against Xanthomonas oryzae pv. oryzae. Artif. Cells Nanomed. Biotechnol. 2019, 47, 341–352. [Google Scholar] [CrossRef] [Green Version]
- Alrajhi, A.H.; Ahmed, N.M.; Al Shafouri, M.; Almessiere, M.A.; Al-Ghamdi, A.A.M. Green synthesis of zinc oxide nanoparticles using salvia officials extract. Mater. Sci. Semicond. Process. 2021, 125, 105641. [Google Scholar] [CrossRef]
- Swamy, V.; Ninge, K.; Sudhakar, R. Antimicrobial activity of Casuarina equisetifolia. Int. J. Innov. Pharm. Dev. 2013, 1, 49–57. [Google Scholar]
- Vaidya, S.K.; Golwala, D.K.; Shrimanker, M.V.; Patel, D.S.; Sahoo, S. Antioxidant and anti-arthritic potential of Casuarina equisetifolia fruit methanolic extract. Eur. J. Med. Plants 2020, 31, 42–53. [Google Scholar] [CrossRef] [Green Version]
- Gowrie, U.K.S. Phytochemical Analysis And In Vitro Studies On Antibacterial, Antioxidant And Anti-Inflammatory Activities Using Casuarina Equisetifolia Bark Extracts. Int. J. Pharm. Pharm. Sci. 2018, 10, 118–125. [Google Scholar] [CrossRef] [Green Version]
- Yulizar, Y.; Utari, T.; Ariyanta, H.A.; Maulina, D. Green method for synthesis of gold nanoparticles using polyscias scutellaria leaf extract under uv light and their catalytic activity to reduce methylene blue. J. Nanomater. 2017, 2017, 3079636. [Google Scholar] [CrossRef] [Green Version]
- Khan, M.J.; Kumari, S.; Shameli, K.; Selamat, J.; Sazili, A.Q. Green synthesis and characterization of pullulan mediated silver nanoparticles through ultraviolet irradiation. Materials 2019, 12, 2382. [Google Scholar] [CrossRef] [Green Version]
- Hassani Sangani, M.; Nakhaei Moghaddam, M.; Forghanifard, M.M. Inhibitory effect of zinc oxide nanoparticles on pseudomonas aeruginosa biofilm formation. Nanomedicine 2015, 2, 121–128. [Google Scholar]
- Hameed, A.S.H.; Karthikeyan, C.; Ahamed, A.P.; Thajuddin, N.; Alharbi, N.S.; Alharbi, S.A.; Ravi, G. In vitro antibacterial activity of ZnO and Nd doped ZnO nanoparticles against ESBL producing Escherichia coli and Klebsiella pneumoniae. Sci. Rep. 2016, 6, 1–11. [Google Scholar] [CrossRef] [PubMed] [Green Version]
- Jain, N.; Bhargava, A.; Panwar, J. Enhanced photocatalytic degradation of methylene blue using biologically synthesized “protein-capped” ZnO nanoparticles. Chem. Eng. J. 2014, 243, 549–555. [Google Scholar] [CrossRef]
- Movahedi, F.; Masrouri, H.; Kassaee, M. Immobilized silver on surface-modified ZnO nanoparticles: As an efficient catalyst for synthesis of propargylamines in water. J. Mol. Catal. A Chem. 2014, 395, 52–57. [Google Scholar] [CrossRef]
- Reddy, L.S.; Nisha, M.M.; Joice, M.; Shilpa, P. Antimicrobial activity of zinc oxide (ZnO) nanoparticle against Klebsiella pneumoniae. Pharm. Biol. 2014, 52, 1388–1397. [Google Scholar] [CrossRef]
- Agarwal, H.; Menon, S.; Kumar, S.V.; Rajeshkumar, S. Mechanistic study on antibacterial action of zinc oxide nanoparticles synthesized using green route. Chem.-Biol. Interact. 2018, 286, 60–70. [Google Scholar] [CrossRef] [PubMed]
- Baek, Y.-W.; An, Y.-J. Microbial toxicity of metal oxide nanoparticles (CuO, NiO, ZnO, and Sb2O3) to Escherichia coli, Bacillus subtilis, and Streptococcus aureus. Sci. Total Environ. 2011, 409, 1603–1608. [Google Scholar] [CrossRef]
- Hanley, C.; Layne, J.; Punnoose, A.; Reddy, K.á.; Coombs, I.; Coombs, A.; Feris, K.; Wingett, D. Preferential killing of cancer cells and activated human T cells using ZnO nanoparticles. Nanotechnology 2008, 19, 295103. [Google Scholar] [CrossRef] [PubMed] [Green Version]
- Tettey, C.O.; Shin, H.M. Evaluation of the antioxidant and cytotoxic activities of zinc oxide nanoparticles synthesized using scutellaria baicalensis root. Sci. Afr. 2019, 6, e00157. [Google Scholar] [CrossRef]
- Saeed, F.; Younas, M.; Fazal, H.; Mushtaq, S.; Rahman, F.u.; Shah, M.; Anjum, S.; Ahmad, N.; Ali, M.; Hano, C.; et al. Green and chemically synthesized zinc oxide nanoparticles: Effects on in-vitro seedlings and callus cultures of Silybum marianum and evaluation of their antimicrobial and anticancer potential. Artif. Cells Nanomed. Biotechnol. 2021, 49, 450–460. [Google Scholar] [CrossRef]
- Kalpana, V.; Devi Rajeswari, V. A review on green synthesis, biomedical applications, and toxicity studies of ZnO NPs. Bioinorg. Chem. Appl. 2018, 2018, 3569758. [Google Scholar] [CrossRef] [PubMed]
- Kummara, S.; Patil, M.B.; Uriah, T. Synthesis, characterization, biocompatible and anticancer activity of green and chemically synthesized silver nanoparticles–a comparative study. Biomed. Pharmacother. 2016, 84, 10–21. [Google Scholar] [CrossRef] [PubMed]
- Kamtekar, S.; Keer, V.; Patil, V. Estimation of phenolic content, flavonoid content, antioxidant and alpha amylase inhibitory activity of marketed polyherbal formulation. J. Appl. Pharm. Sci. 2014, 4, 61–65. [Google Scholar] [CrossRef]
- Aryal, S.; Baniya, M.K.; Danekhu, K.; Kunwar, P.; Gurung, R.; Koirala, N. Total Phenolic Content, Flavonoid Content and Antioxidant Potential of Wild Vegetables from Western Nepal. Plants 2019, 8, 96. [Google Scholar] [CrossRef] [Green Version]
- Anjum, S.; Abbasi, B.H.; Hano, C. Trends in accumulation of pharmacologically important antioxidant-secondary metabolites in callus cultures of Linum usitatissimum L. Plant Cell Tissue Organ Cult. 2017, 129, 73–87. [Google Scholar] [CrossRef]
- Abbasi, B.; Anjum, S.; Hano, C. Differential effects of in vitro cultures of Linum usitatissimum L. (Flax) on biosynthesis, stability, antibacterial and antileishmanial activities of zinc oxide nanoparticles: A mechanistic approach. RSC Adv. 2017, 7, 15931–15943. [Google Scholar] [CrossRef] [Green Version]
- Tungmunnithum, D.; Renouard, S.; Drouet, S.; Blondeau, J.-P.; Hano, C. A critical cross-species comparison of pollen from Nelumbo nucifera Gaertn. vs. Nymphaea lotus L. for authentication of Thai medicinal herbal tea. Plants 2020, 9, 921. [Google Scholar] [CrossRef]
- Fakhari, S.; Jamzad, M.; Kabiri Fard, H. Green synthesis of zinc oxide nanoparticles: A comparison. Green Chem. Lett. Rev. 2019, 12, 19–24. [Google Scholar] [CrossRef] [Green Version]
- Nazir, M.; Tungmunnithum, D.; Bose, S.; Drouet, S.; Garros, L.; Giglioli-Guivarc’h, N.; Abbasi, B.H.; Hano, C. Differential production of phenylpropanoid metabolites in callus cultures of Ocimum basilicum L. with distinct in vitro antioxidant activities and in vivo protective effects against UV stress. J. Agric. Food Chem. 2019, 67, 1847–1859. [Google Scholar] [CrossRef] [PubMed]
- Ahmed, M.; Fatima, H.; Qasim, M.; Gul, B.; Haq, I. Polarity directed optimization of phytochemical and in vitro biological potential of an indigenous folklore: Quercus dilatata Lindl. ex Royle. BMC Complement. Altern. Med. 2017, 17, 1–16. [Google Scholar] [CrossRef] [PubMed]
- Khalil, A.T.; Ovais, M.; Ullah, I.; Ali, M.; Shinwari, Z.K.; Khamlich, S.; Maaza, M. Sageretia thea (Osbeck.) mediated synthesis of zinc oxide nanoparticles and its biological applications. Nanomedicine 2017, 12, 1767–1789. [Google Scholar] [CrossRef] [PubMed]
- Soobrattee, M.A.; Neergheen, V.S.; Luximon-Ramma, A.; Aruoma, O.I.; Bahorun, T. Phenolics as potential antioxidant therapeutic agents: Mechanism and actions. Mutat. Res./Fundam. Mol. Mech. Mutagenesis 2005, 579, 200–213. [Google Scholar] [CrossRef] [PubMed]
- Chandra, S.; Khan, S.; Avula, B.; Lata, H.; Yang, M.; Elsohly, M.; Khan, I. Assessment of Total Phenolic and Flavonoid Content, Antioxidant Properties, and Yield of Aeroponically and Conventionally Grown Leafy Vegetables and Fruit Crops: A Comparative Study. Evid.-Based Complementary Altern. Med. 2014, 2014, 253875. [Google Scholar] [CrossRef]
- Brist, N.J.; Islam, M.F.; Anisuzzaman, S.M.; Alam, M.N. Antioxidant activity of the water extracts of leaves, root barks, barks of Casuarina littorea. Aust. J. Basic Appl. Sci. 2014, 8, 419–426. [Google Scholar]
- Khan, A.K.; Kousar, S.; Tungmunnithum, D.; Hano, C.; Abbasi, B.H.; Anjum, S. Nano-Elicitation as an Effective and Emerging Strategy for In Vitro Production of Industrially Important Flavonoids. Appl. Sci. 2021, 11, 1694. [Google Scholar] [CrossRef]
- Kumar, S.; Mishra, A.; Pandey, A.K. Antioxidant mediated protective effect of Parthenium hysterophorus against oxidative damage using in vitro models. BMC Complementary Altern. Med. 2013, 13, 120. [Google Scholar] [CrossRef] [Green Version]
- Alam, M.N.; Roy, S.; Anisuzzaman, S.M.; Rafiquzzaman, M. Antioxidant activity of the ethanolic extracts of leaves, stems and fruits of Solanum nigrum. Pharmacogn. Commun. 2012, 2, 67–71. [Google Scholar] [CrossRef] [Green Version]
- Koleva, I.I.; Van Beek, T.A.; Linssen, J.P.; Groot, A.d.; Evstatieva, L.N. Screening of plant extracts for antioxidant activity: A comparative study on three testing methods. Phytochem. Anal. Int. J. Plant Chem. Biochem. Technol. 2002, 13, 8–17. [Google Scholar] [CrossRef]
- Ezealisiji, K.M.; Siwe-Noundou, X.; Maduelosi, B.; Nwachukwu, N.; Krause, R.W.M. Green synthesis of zinc oxide nanoparticles using Solanum torvum (L) leaf extract and evaluation of the toxicological profile of the ZnO nanoparticles–hydrogel composite in Wistar albino rats. Int. Nano Lett. 2019, 9, 99–107. [Google Scholar] [CrossRef] [Green Version]
- Xie, F.; Zhang, T.; Bryant, P.; Kurusingal, V.; Colwell, J.M.; Laycock, B. Degradation and stabilization of polyurethane elastomers. Prog. Polym. Sci. 2019, 90, 211–268. [Google Scholar] [CrossRef]
- Rastogi, L.; Arunachalam, J. Sunlight based irradiation strategy for rapid green synthesis of highly stable silver nanoparticles using aqueous garlic (Allium sativum) extract and their antibacterial potential. Mater. Chem. Phys. 2011, 129, 558–563. [Google Scholar] [CrossRef]
- Fahimmunisha, B.A.; Ishwarya, R.; AlSalhi, M.S.; Devanesan, S.; Govindarajan, M.; Vaseeharan, B. Green fabrication, characterization and antibacterial potential of zinc oxide nanoparticles using Aloe socotrina leaf extract: A novel drug delivery approach. J. Drug Deliv. Sci. Technol. 2020, 55, 101465. [Google Scholar] [CrossRef]
- Selim, Y.A.; Azb, M.A.; Ragab, I.; Abd El-Azim, M.H. Green synthesis of zinc oxide nanoparticles using aqueous extract of Deverra tortuosa and their cytotoxic activities. Sci. Rep. 2020, 10, 1–9. [Google Scholar]
- Priyadharshini, R.I.; Prasannaraj, G.; Geetha, N.; Venkatachalam, P. Microwave-Mediated Extracellular Synthesis of Metallic Silver and Zinc Oxide Nanoparticles Using Macro-Algae (Gracilaria edulis) Extracts and Its Anticancer Activity Against Human PC3 Cell Lines. Appl. Biochem. Biotechnol. 2014, 174, 2777–2790. [Google Scholar] [CrossRef] [PubMed]
- Chikkanna, M.M.; Neelagund, S.E.; Rajashekarappa, K.K. Green synthesis of Zinc oxide nanoparticles (ZnO NPs) and their biological activity. SN Appl. Sci. 2018, 1, 117. [Google Scholar] [CrossRef] [Green Version]
- Filip, G.A.; Moldovan, B.; Baldea, I.; Olteanu, D.; Suharoschi, R.; Decea, N.; Cismaru, C.M.; Gal, E.; Cenariu, M.; Clichici, S. UV-light mediated green synthesis of silver and gold nanoparticles using Cornelian cherry fruit extract and their comparative effects in experimental inflammation. J. Photochem. Photobiol. B Biol. 2019, 191, 26–37. [Google Scholar] [CrossRef]
- Santhoshkumar, J.; Kumar, S.V.; Rajeshkumar, S. Synthesis of zinc oxide nanoparticles using plant leaf extract against urinary tract infection pathogen. Resour.-Effic. Technol. 2017, 3, 459–465. [Google Scholar] [CrossRef]
- Pan, C.-H.; Liu, W.-T.; Bien, M.-Y.; Lin, I.-C.; Hsiao, T.-C.; Ma, C.-M.; Lai, C.-H.; Chen, M.-C.; Chuang, K.-J.; Chuang, H.-C. Effects of size and surface of zinc oxide and aluminum-doped zinc oxide nanoparticles on cell viability inferred by proteomic analyses. Int. J. Nanomed. 2014, 9, 3631–3643. [Google Scholar]
- Łukowiec, D.; Radoń, A. Self-organization of silver nanoparticles during synthesis of Ag–Au nanoalloy by UV irradiation method. J. Mater. Sci. 2020, 55, 2796–2801. [Google Scholar] [CrossRef] [Green Version]
- Shabaani, M.; Rahaiee, S.; Zare, M.; Jafari, S.M. Green synthesis of ZnO nanoparticles using loquat seed extract; Biological functions and photocatalytic degradation properties. LWT 2020, 134, 110133. [Google Scholar] [CrossRef]
- Gupta, M.; Tomar, R.S.; Kaushik, S.; Mishra, R.K.; Sharma, D. Effective antimicrobial activity of green ZnO nano particles of Catharanthus roseus. Front. Microbiol. 2018, 9, 2030. [Google Scholar] [CrossRef] [PubMed]
- Soares, V.; Xavier, M.; Rodrigues, E.; de Oliveira, C.; Farias, P.; Stingl, A.; Ferreira, N.; Silva, M. Green synthesis of ZnO nanoparticles using whey as an effective chelating agent. Mater. Lett. 2020, 259, 126853. [Google Scholar] [CrossRef]
- Gawade, V.V.; Gavade, N.L.; Shinde, H.M.; Babar, S.B.; Kadam, A.N.; Garadkar, K.M. Green synthesis of ZnO nanoparticles by using Calotropis procera leaves for the photodegradation of methyl orange. J. Mater. Sci. Mater. Electron. 2017, 28, 14033–14039. [Google Scholar] [CrossRef]
- Jiang, J.; Pi, J.; Cai, J. The advancing of zinc oxide nanoparticles for biomedical applications. Bioinorg. Chem. Appl. 2018, 2018, 1062562. [Google Scholar] [CrossRef] [PubMed]
- Singh, A.; Gautam, P.K.; Verma, A.; Singh, V.; Shivapriya, P.M.; Shivalkar, S.; Sahoo, A.K.; Samanta, S.K. Green synthesis of metallic nanoparticles as effective alternatives to treat antibiotics resistant bacterial infections: A review. Biotechnol. Rep. 2020, 25, e00427. [Google Scholar] [CrossRef]
- Singh, R.; Cheng, S.; Singh, S. Oxidative stress-mediated genotoxic effect of zinc oxide nanoparticles on Deinococcus radiodurans. 3 Biotech 2020, 10, 1–13. [Google Scholar] [CrossRef] [Green Version]
- Padmavathy, N.; Vijayaraghavan, R. Enhanced bioactivity of ZnO nanoparticles—an antimicrobial study. Sci. Technol. Adv. Mater. 2008, 9, 035004. [Google Scholar] [CrossRef] [PubMed]
- Elkady, M.; Shokry Hassan, H.; Hafez, E.E.; Fouad, A. Construction of zinc oxide into different morphological structures to be utilized as antimicrobial agent against multidrug resistant bacteria. Bioinorg. Chem. Appl. 2015, 2015, 536854. [Google Scholar] [CrossRef] [Green Version]
- Bharathi, D.; Bhuvaneshwari, V. Synthesis of zinc oxide nanoparticles (ZnO NPs) using pure bioflavonoid rutin and their biomedical applications: Antibacterial, antioxidant and cytotoxic activities. Res. Chem. Intermed. 2019, 45, 2065–2078. [Google Scholar] [CrossRef]
- Mirhosseini, M.; Firouzabadi, F.B. Antibacterial activity of zinc oxide nanoparticle suspensions on food-borne pathogens. Int. J. Dairy Technol. 2013, 66, 291–295. [Google Scholar] [CrossRef]
- Ganeshan, G.; Manoj Kumar, A. Pseudomonas fluorescens, a potential bacterial antagonist to control plant diseases. J. Plant Interact. 2005, 1, 123–134. [Google Scholar] [CrossRef]
- Kumar, H.; Franzetti, L.; Kaushal, A.; Kumar, D. Pseudomonas fluorescens: A potential food spoiler and challenges and advances in its detection. Ann. Microbiol. 2019, 69, 873–883. [Google Scholar] [CrossRef]
- Andreani, N.A.; Carraro, L.; Martino, M.E.; Fondi, M.; Fasolato, L.; Miotto, G.; Magro, M.; Vianello, F.; Cardazzo, B. A genomic and transcriptomic approach to investigate the blue pigment phenotype in Pseudomonas fluorescens. Int. J. Food Microbiol. 2015, 213, 88–98. [Google Scholar] [CrossRef] [Green Version]
- Azizi-Lalabadi, M.; Ehsani, A.; Divband, B.; Alizadeh-Sani, M. Antimicrobial activity of Titanium dioxide and Zinc oxide nanoparticles supported in 4A zeolite and evaluation the morphological characteristic. Sci. Rep. 2019, 9, 17439. [Google Scholar] [CrossRef] [Green Version]
- Bassetti, M.; Vena, A.; Croxatto, A.; Righi, E.; Guery, B. How to manage Pseudomonas aeruginosa infections. Drugs Context 2018, 7, 212527. [Google Scholar] [CrossRef]
- Tayel, A.A.; EL-TRAS, W.F.; Moussa, S.; EL-BAZ, A.F.; Mahrous, H.; Salem, M.F.; Brimer, L. Antibacterial action of zinc oxide nanoparticles against foodborne pathogens. J. Food Saf. 2011, 31, 211–218. [Google Scholar] [CrossRef]
- Abbasi, B.H.; Shah, M.; Hashmi, S.S.; Nazir, M.; Naz, S.; Ahmad, W.; Khan, I.U.; Hano, C. Green Bio-Assisted Synthesis, Characterization and Biological Evaluation of Biocompatible ZnO NPs Synthesized from Different Tissues of Milk Thistle (Silybum marianum). Nanomaterials 2019, 9, 1171. [Google Scholar] [CrossRef] [Green Version]
- Fang, I.J.; Trewyn, B.G. Chapter three—Application of Mesoporous Silica Nanoparticles in Intracellular Delivery of Molecules and Proteins. In Methods in Enzymology; Düzgüneş, N., Ed.; Academic Press: Cambridge, MA, USA, 2012; Volume 508, pp. 41–59. [Google Scholar]
- Chen, P.; Wang, H.; He, M.; Chen, B.; Yang, B.; Hu, B. Size-dependent cytotoxicity study of ZnO nanoparticles in HepG2 cells. Ecotoxicol. Environ. Saf. 2019, 171, 337–346. [Google Scholar] [CrossRef] [PubMed]
- Leutner, S.; Eckert, A.; Müller, W. ROS generation, lipid peroxidation and antioxidant enzyme activities in the aging brain. J. Neural Transm. 2001, 108, 955–967. [Google Scholar] [CrossRef]
- Wang, C.; Hu, X.; Gao, Y.; Ji, Y. ZnO nanoparticles treatment induces apoptosis by increasing intracellular ROS levels in LTEP-a-2 cells. BioMed Res. Int. 2015, 2015, 423287. [Google Scholar] [CrossRef] [Green Version]
- Nakkala, J.R.; Mata, R.; Raja, K.; Chandra, V.K.; Sadras, S.R. Green synthesized silver nanoparticles: Catalytic dye degradation, in vitro anticancer activity and in vivo toxicity in rats. Mater. Sci. Eng. C 2018, 91, 372–381. [Google Scholar] [CrossRef]
- Chen, H.; Luo, L.; Fan, S.; Xiong, Y.; Ling, Y.; Peng, S. Zinc oxide nanoparticles synthesized from Aspergillus terreus induces oxidative stress-mediated apoptosis through modulating apoptotic proteins in human cervical cancer HeLa cells. J. Pharm. Pharmacol. 2021, 73, 221–232. [Google Scholar] [CrossRef]
- Walsh, J.G.; Cullen, S.P.; Sheridan, C.; Lüthi, A.U.; Gerner, C.; Martin, S.J. Executioner caspase-3 and caspase-7 are functionally distinct proteases. Proc. Natl. Acad. Sci. USA 2008, 105, 12815–12819. [Google Scholar] [CrossRef] [Green Version]
- Tang, Q.; Xia, H.; Liang, W.; Huo, X.; Wei, X. Synthesis and characterization of zinc oxide nanoparticles from Morus nigra and its anticancer activity of AGS gastric cancer cells. J. Photochem. Photobiol. B Biol. 2020, 202, 111698. [Google Scholar] [CrossRef] [PubMed]
- Duan, X.; Liao, Y.; Liu, T.; Yang, H.; Liu, Y.; Chen, Y.; Ullah, R.; Wu, T. Zinc oxide nanoparticles synthesized from Cardiospermum halicacabum and its anticancer activity in human melanoma cells (A375) through the modulation of apoptosis pathway. J. Photochem. Photobiol. B Biol. 2020, 202, 111718. [Google Scholar] [CrossRef] [PubMed]
- Le Marchand, L. Cancer preventive effects of flavonoids—A review. Biomed. Pharmacother. 2002, 56, 296–301. [Google Scholar] [CrossRef]
- Treuel, L.; Jiang, X.; Nienhaus, G.U. New views on cellular uptake and trafficking of manufactured nanoparticles. J. R. Soc. Interface 2013, 10, 20120939. [Google Scholar] [CrossRef] [PubMed]
- Oh, N.; Park, J.-H. Endocytosis and exocytosis of nanoparticles in mammalian cells. Int. J. Nanomed. 2014, 9, 51. [Google Scholar]
- Bisht, G.; Rayamajhi, S. ZnO nanoparticles: A promising anticancer agent. Nanobiomedicine 2016, 3, 3–9. [Google Scholar] [CrossRef]
- Zhu, S.; Gong, L.; Li, Y.; Xu, H.; Gu, Z.; Zhao, Y. Safety Assessment of Nanomaterials to Eyes: An Important but Neglected Issue. Adv. Sci. 2019, 6, 1802289. [Google Scholar] [CrossRef]
- Yu, K.-N.; Yoon, T.-J.; Minai-Tehrani, A.; Kim, J.-E.; Park, S.J.; Jeong, M.S.; Ha, S.-W.; Lee, J.-K.; Kim, J.S.; Cho, M.-H. Zinc oxide nanoparticle induced autophagic cell death and mitochondrial damage via reactive oxygen species generation. Toxicol. Vitr. 2013, 27, 1187–1195. [Google Scholar] [CrossRef]
- Javed, B.; Ikram, M.; Farooq, F.; Sultana, T.; Raja, N.I. Biogenesis of silver nanoparticles to treat cancer, diabetes, and microbial infections: A mechanistic overview. Appl. Microbiol. Biotechnol. 2021, 105, 1–15. [Google Scholar] [CrossRef] [PubMed]
- Chen, G.; Li, S.-Y.; Malik, H.T.; Ma, Y.-G.; Xu, H.; Sun, L.-K. Organic two-photon nanoparticles modulate reactive oxygen species, intracellular calcium concentration, and mitochondrial membrane potential during apoptosis of human gastric carcinoma SGC-7901 cells. Biotechnol. Lett. 2016, 38, 1269–1276. [Google Scholar] [CrossRef] [PubMed]
- Syama, S.; Sreekanth, P.J.; Varma, H.K.; Mohanan, P.V. Zinc oxide nanoparticles induced oxidative stress in mouse bone marrow mesenchymal stem cells. Toxicol. Mech. Methods 2014, 24, 644–653. [Google Scholar] [CrossRef]
- Rager, J.E. Chapter 8—The Role of Apoptosis-Associated Pathways as Responders to Contaminants and in Disease Progression. In Systems Biology in Toxicology and Environmental Health; Fry, R.C., Ed.; Academic Press: Boston, MA, USA, 2015; pp. 187–205. [Google Scholar] [CrossRef]
- Hnamte, S.; Kaviyarasu, K.; Siddhardha, B. Evaluation of Toxicity of Nanoparticles Using Brine Shrimp. In Model Organisms to Study Biological Activities and Toxicity of Nanoparticles; Siddhardha, B., Dyavaiah, M., Kasinathan, K., Eds.; Springer: Singapore, 2020; pp. 401–415. [Google Scholar] [CrossRef]
- Mohamed, H.E.A.; Afridi, S.; Khalil, A.T.; Zia, D.; Shinwari, Z.K.; Dhlamini, M.S.; Maaza, M. Structural, Morphological and Biological Features of ZnO Nanoparticles Using Hyphaene thebaica (L.) Mart. Fruits. J. Inorg. Organomet. Polym. Mater. 2020, 30, 3241–3254. [Google Scholar] [CrossRef]
- Dobretsov, S.; Sathe, P.; Bora, T.; Barry, M.; Myint, M.T.Z.; Abri, M. Toxicity of different zinc oxide nanomaterials at three trophic levels: Implications for development of low-toxicity antifouling agents. Environ. Toxicol. Chem. 2020, 39, 1343–1354. [Google Scholar] [CrossRef] [PubMed]
- Hemanth Kumar, N.K.; Murali, M.; Satish, A.; Brijesh Singh, S.; Gowtham, H.G.; Mahesh, H.M.; Lakshmeesha, T.R.; Amruthesh, K.N.; Jagannath, S. Bioactive and Biocompatible Nature of Green Synthesized Zinc Oxide Nanoparticles from Simarouba glauca DC.: An Endemic Plant to Western Ghats, India. J. Clust. Sci. 2020, 31, 523–534. [Google Scholar] [CrossRef]
- Zare, M.; Keerthiraj, D.N.; Thakur, M.; Byrappa, K. Biocompatibility Assessment and Photocatalytic Activity of Bio-hydrothermal Synthesis of ZnO Nanoparticles by Thymus vulgaris Leaf Extract. Mater. Res. Bull. 2018, 109, 49–59. [Google Scholar] [CrossRef]

| Bacterial Strain | Sample Type | Mean of Zone of Inhibition (mm) (15 μL/well) | ||
|---|---|---|---|---|
| CE-ZnONPs | CE-UV-A-ZnONPs | CE-UV-C-ZnONPs | ||
| Bacillus subtilis | Negative Control | 0 | 0 | 0 |
| Positive Control (ZnAc) | 11 | 11 | 10 | |
| ZnONPs | 11 | 10 | 12 | |
| Standard Amp disc | 8 | 8 | 8 | |
| Pseudomonas fluorescens | Negative Control | 1 | 1 | 1 |
| Positive Control (ZnAc) | 10 | 10 | 10.5 | |
| ZnONPs | 9 | 8.5 | 9.5 | |
| Standard Amp disc | 7 | 7.5 | 8.5 | |
| Pseudomonas aeruginosa | Negative Control | 1 | 1 | 1 |
| Positive Control (ZnAc) | 9 | 9 | 9 | |
| ZnONPs | 10.5 | 12 | 15 | |
| Standard Amp disc | 7 | 8 | 7 | |
Publisher’s Note: MDPI stays neutral with regard to jurisdictional claims in published maps and institutional affiliations. |
© 2021 by the authors. Licensee MDPI, Basel, Switzerland. This article is an open access article distributed under the terms and conditions of the Creative Commons Attribution (CC BY) license (https://creativecommons.org/licenses/by/4.0/).
Share and Cite
Khan, A.K.; Renouard, S.; Drouet, S.; Blondeau, J.-P.; Anjum, I.; Hano, C.; Abbasi, B.H.; Anjum, S. Effect of UV Irradiation (A and C) on Casuarina equisetifolia-Mediated Biosynthesis and Characterization of Antimicrobial and Anticancer Activity of Biocompatible Zinc Oxide Nanoparticles. Pharmaceutics 2021, 13, 1977. https://doi.org/10.3390/pharmaceutics13111977
Khan AK, Renouard S, Drouet S, Blondeau J-P, Anjum I, Hano C, Abbasi BH, Anjum S. Effect of UV Irradiation (A and C) on Casuarina equisetifolia-Mediated Biosynthesis and Characterization of Antimicrobial and Anticancer Activity of Biocompatible Zinc Oxide Nanoparticles. Pharmaceutics. 2021; 13(11):1977. https://doi.org/10.3390/pharmaceutics13111977
Chicago/Turabian StyleKhan, Amna Komal, Sullivan Renouard, Samantha Drouet, Jean-Philippe Blondeau, Iram Anjum, Christophe Hano, Bilal Haider Abbasi, and Sumaira Anjum. 2021. "Effect of UV Irradiation (A and C) on Casuarina equisetifolia-Mediated Biosynthesis and Characterization of Antimicrobial and Anticancer Activity of Biocompatible Zinc Oxide Nanoparticles" Pharmaceutics 13, no. 11: 1977. https://doi.org/10.3390/pharmaceutics13111977
APA StyleKhan, A. K., Renouard, S., Drouet, S., Blondeau, J.-P., Anjum, I., Hano, C., Abbasi, B. H., & Anjum, S. (2021). Effect of UV Irradiation (A and C) on Casuarina equisetifolia-Mediated Biosynthesis and Characterization of Antimicrobial and Anticancer Activity of Biocompatible Zinc Oxide Nanoparticles. Pharmaceutics, 13(11), 1977. https://doi.org/10.3390/pharmaceutics13111977








